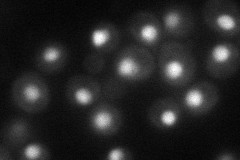
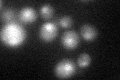
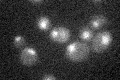

View description
Homodimeric Zn2Cys6 zinc finger transcription factor; binds to a weak acid response element to induce transcription of PDR12 and FUN34, encoding an acid transporter and a putative ammonia transporter, respectively
Localization:
Intensity:
Fold change:
Significance:
-
C’ GFP library in SD

nucleus21.55 -
N' NOP1pr-GFP in SD
nucleus48.0662 -
N' TEF2pr-mCherry in SD

nucleus51.2158 -
N' NATIVEpr-GFP in SD

nucleus20.8082 -
N' TEF2pr-VC and Cyto-VN in SD

nucleus35.6851 -
C’ GFP library in SD+DTT
nucleus21.941.01No -
C’ GFP library in SD+H2O2

nucleus23.821.1No -
C’ GFP library in Starvation Media
nucleus20.070.93No -
C’ GFP library on the background of Pup2-DaMP

nucleus -
C’ GFP library on the background of CCT mutant

nucleus29.331.36023No
